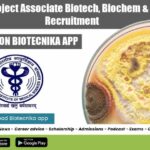
AIIMS Delhi Project Associate

Home Search
biology - search results
If you're not happy with the results, please do another search
HCCB Microbiology Quality Assurance Executive Recruitment, Apply Online
HCCB Microbiology Quality Assurance Executive Recruitment, Apply Online
HCCB Microbiology Quality Assurance Executive Recruitment, Apply Online. Hindustan Coca-Cola Beverages Pvt. Ltd. jobs. QA Vacancies. Executive...
CSIR-NEERI Project Associate Job Opening For Biotech & Microbiology
CSIR-NEERI Project Associate Job Opening For Biotech & Microbiology
CSIR-NEERI Project Associate Job Opening For Biotech & Microbiology. MSc biotechnology, microbiology project associate job at...
PI Industries Cell Biology Analyst Job For Biotech & Life Sciences
PI Industries Cell Biology Analyst Job For Biotech & Life Sciences
PI Industries Cell Biology Analyst Job For Biotech & Life Sciences. MSc Biotechnology...
IISER Pune Hiring Biochem, Biotech, Molecular Microbiology For Research Vacancies
IISER Pune Hiring Biochem, Biotech, Molecular Microbiology For Research Vacancies
IISER Pune Hiring Biochem, Biotech, Molecular Microbiology For Research Vacancies. Research Associate (RA) / Senior...
Government RGCB Biology, Biotech & Biochem Research Fellow Recruitment
Government RGCB Biology, Biotech & Biochem Research Fellow Recruitment
Government RGCB Biology, Biotech & Biochem Research Fellow Recruitment. Rajiv Gandhi Centre for Biology/Biotechnology/Biochemistry JRF Job....
Bhavan’s Research Center (BRC) for Microbiology Recruitment
Bhavan’s Research Center (BRC) for Microbiology R&D Recruitment
About Us
Bhavan’s Research Center (BRC) for Microbiology, established in 2005, has its genesis in the Department of...
NIPER JRF Job For Biotech, Biochem, Microbiology, Life Sciences
NIPER JRF Job For Biotech, Biochem, Microbiology, Life Sciences
NIPER JRF Job For Biotech, Biochem, Microbiology, Life Sciences. National Institute of Pharmaceutical Education & Research,...
MACS-ARI Pune Biotech & Microbiology JRF Recruitment
MACS-ARI Pune Biotech & Microbiology JRF Recruitment
MACS-ARI Pune Biotech & Microbiology JRF Recruitment. JRF jobs at MACS-ARI Pune. MSc Biotechnology and Microbiology JRF Job....
Quantumzyme Looking For Intern Computational Biology, Apply Online
Quantumzyme Intern Computational Biology, Apply Online
Quantumzyme Intern Computational Biology, Apply Online. Computational Biology Internship. Internships for Bioinformatics. Computational Biology Internships. MSc Bioinformatics Internships. Bioinformatics...
Internship Opportunity for Freshers @ BioTecNika in Molecular Biology Techniques, Check How to apply
Internship Opportunity for Freshers @ BioTecNika in Molecular Biology Techniques, Check How to apply
Molecular Biology Techniques Internship
If you don’t learn, then you won’t earn
Importance...
CIAB Fellowships For MSc/ MTech/ BE & BTech Biotech, Microbiology
CIAB Fellowships For MSc/ MTech/ BE & BTech Biotech, Microbiology
CIAB Fellowships For MSc/ MTech/ BE & BTech Biotech, Microbiology. MSc/ MTech/ BE & BTech...
IARI JRF & Young Professional Job Openings For Microbiology, Life Sciences, Biochemistry
IARI JRF & Young Professional Job Openings For Microbiology, Life Sciences, Biochemistry
IARI JRF & Young Professional Job Openings For Microbiology, Life Sciences, Biochemistry. MSc...
AIIMS Delhi Project Associate Biotech, Biochem & Microbiology Recruitment
AIIMS Delhi Project Associate Biotech, Biochem & Microbiology Recruitment
AIIMS Delhi Project Associate Biotech, Biochem & Microbiology Recruitment. Project Associate Microbiology/ Biotechnology/ Biochemistry job. Interested...
JNCASR Biology & Biochem Research Associate Jobs With Up To Rs. 47,000 pm Pay
JNCASR Research Associate Jobs, Applications Invited
JNCASR Research Associate Jobs, Applications Invited. MSc & PhD Biochem, Biology research associate positions at JNCASR. JNCASR Research jobs...
Govt RGCB Microbiology, Biotechnology Research Fellow Recruitment
RGCB Microbiology JRF - Life Sciences Also Eligible To Apply
RGCB Microbiology JRF - Life Sciences Also Eligible To Apply. Rajiv Gandhi Centre for Biotechnology...